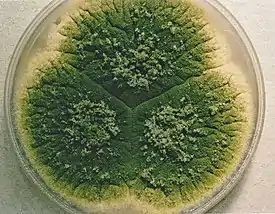

Аспергилл паразитический
Асперги́лл паразити́ческий (лат. Aspergíllus parasíticus) — вид гетероталличных грибов-аскомицетов, относящийся к роду Аспергилл (Aspergillus). Ранее это название применялось только к анаморфной стадии гриба.
| Аспергилл паразитический | ||||||||||
|---|---|---|---|---|---|---|---|---|---|---|
| ||||||||||
| Научная классификация | ||||||||||
|
Домен: Царство: Подцарство: Отдел: Подотдел: Класс: Подкласс: Eurotiomycetidae Порядок: Семейство: Aspergillaceae Род: Секция: Flavi Вид: Аспергилл паразитический |
||||||||||
| Международное научное название | ||||||||||
| Aspergillus parasiticus Speare, 1912 | ||||||||||
| ||||||||||
Продуцент опасных микотоксинов — афлатоксинов.
Описание
Колонии на агаре Чапека с дрожжевым экстрактом (CYA) 5—7 см в диаметре на 7-е сутки, бархатистые, с обильным спороношением по всей поверхности в тёмно-жёлто-зелёных тонах. Иногда образует склероции — беловатые, затем чёрные, иногда покрывающие почти всю колонию (тогда конидиальное спороношение слабовыраженное), шаровидные, 400—800 мкм в диаметре. Реверс неокрашенный или коричневый. При 37° C колонии очень широкорастущие, сходные с колониями, образующимися при 25 °C, с более насыщенно-зелёным или коричневатым спороношением. На агаре с солодовым экстрактом (MEA) колонии 5—6,5 см в диаметре на 7-е сутки, обычно менее густые, чем на CYA.
Конидиеносные головки обыкновенно одноярусные, но иногда с примесью двухъярусных, с неокрашенной или коричневатой ножкой 400—800 мкм длиной, с шаровидным апикальным вздутием до 20—35 мкм. Фиалиды 7—11 мкм длиной. Конидии шаровидные, одинаковые, грубошероховатые до шиповатых, 4—6 мкм в диаметре.
Телеоморфа на смешанно-зерновом агаре (MCA) образует жёсткие склероциевидные стромы с клейстотециями, из которых часто только меньшая часть несёт аски со спорами. Аски обычно восьмиспоровые (но нередко с 1—6 спорами), 19—29 × 16—27 мкм. Аскоспоры сплюснутые, шаровидные до широкоэллипсоидальных, мелкобородавчатые, с узким экваториальным гребнем, 7—13 × 6,5—12 мкм.
Отличия от близких видов
Aspergillus flavus отличается несколько неравными конидиями с мелкошероховатыми тонкими стенками, часто образует конидиеносцы с более крупными вздутиями, обычно несущими метулы и фиалиды. Aspergillus sojae, представляющий собой введённую в культуру форму A. parasiticus, морфологически практически неотличим, однако не продуцирует афлатоксины.
Экология
Повсеместно распространённый гриб, наиболее часто выделяемый из тропических регионов, однако отсутствующий в Юго-Восточной Азии. Обнаруживается в почве, на плодах и семенах, на растительных остатках, на пищевых продуктах.
Основной продуцент афлатоксинов B1, B2, G1, G2, вызывающих поражения почек и печени, а также обладающих гепатоканцерогенным и тератогенным эффектом.
Таксономия
Aspergillus parasiticus Speare, Bull. Div. Pathol. Physiol. Hawaiian Sugar Planters Assoc. Exp. Sta. 12: 38 (1912).
Синонимы
- Aspergillus americanus (Marchal & É.J.Marchal) Kozak., 1989
- Aspergillus chungii Y.K.Shih, 1936
- Aspergillus flavus subsp. parasiticus (Speare) Kurtzman et al., 1986
- Aspergillus parasiticus var. globosus Murak., 1966
- Aspergillus terricola var. americanus Marchal & É.J.Marchal, 1921
- Aspergillus toxicarius Murak., 1971
- Petromyces parasiticus B.W.Horn et al., 2009
Примечания
Литература
- Horn B. W., Ramirez-Prado J. H., Carbone I. The sexual state of Aspergillus parasiticus // Mycologia. — 2009. — Vol. 101 (2). — P. 275—280. — doi:10.3852/08-205.
- Pitt J. I., Hocking A. D. Fungi and Food Spoilage. — Springer, 2009. — P. 321—323. — ISBN 978-0-387-92206-5. — doi:10.1007/978-0-387-92207-2.